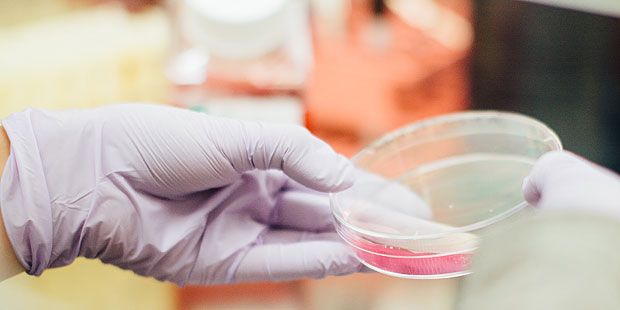

đŹ Gynekologiska cellprover kan upptĂ€cka bröst- och Ă€ggstockscancer
Cellprover frÄn livmoderhalsen kan identifiera risker för fler cancerformer Àn bara livmoderhalscancer.
Dela artikeln
Idag tar vÄrden rutinmÀssigt cellprover frÄn livmoderhalsen för att upptÀcka livmoderhalscancer. Men nu har ett internationellt forskarlag frÄn bland annat Karolinska Institutet utvecklat en metod, som de kallar WID-test, för att anvÀnda dessa prover för att Àven identifiera risk för bröst- och Àggstockscancer.
â Det unika i dessa studier Ă€r att vi hittat ett sĂ€tt att mĂ€ta risk för cancer i andra vĂ€vnader Ă€n dem vi provtagit. Det ger nya insikter i hur cancer uppkommer och öppnar för möjligheten att kunna förutsĂ€ga risk för cancer mer allmĂ€nt i stĂ€llet för en cancerform i taget, sĂ€ger Joakim Dillner, professor vid Karolinska Institutet och en av studiens författare, i ett pressmeddelande.
Metoden fungerar sÄ att forskarna analyserar epigenetiska förÀndringar i livmoderhalsproverna. Det rör sig om förÀndringar i genuttryck som pÄverkats av faktorer som miljö, livsstil och Äldrande.
Forskarna analyserade prover frÄn över tusen kvinnor. Resultatet blev att de lyckades hitta tvÄ unika epigenetiska signaturer som identifierade 76,6 procent av kvinnorna med hög risk för bröstcancer och 61,7 procent med hög risk för Àggstockscancer. Det innebÀr att WID-testet kan upptÀcka upp till 30 procent fler kvinnor med bröst- eller Àggstockscancer Àn dagens metoder.
Resultaten ger nu förhoppningar om att WID-testet ska kunna ge möjlighet till bÀttre behandlingar av mÄnga typer av cancer.
â Om vi vet vilka individer som har en ökad risk att utveckla en viss typ av cancer sĂ„ öppnar det för möjligheten till utökad screening och förebyggande behandling, sĂ€ger medförfattaren Kristina Gemzell Danielsson, professor vid Karolinska Institutet och en av forskarna bakom studien.